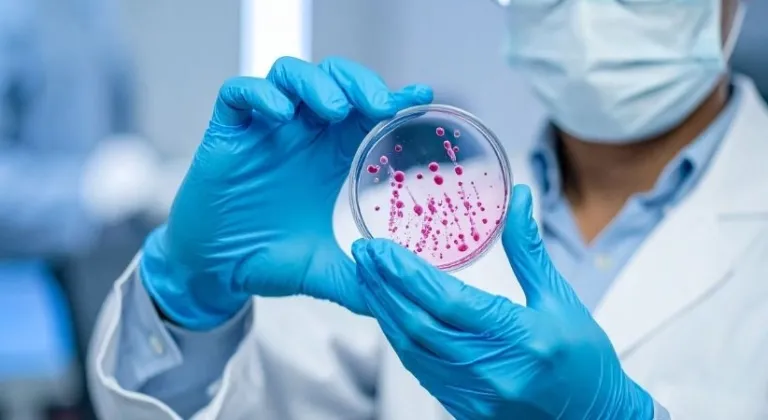
Cipro 500 mg nedir, ne işe yarar, kimler kullanır ve fiyatı ne kadar?

Bakteriyel enfeksiyonların tedavisinde sıkça başvurulan ilaçlardan biri olan Cipro 500 mg, etki alanı ve kullanım şartlarıyla dikkat çekiyor. Peki Cipro 500 mg nedir, hangi hastalıklarda kullanılır, kimler için uygundur ve eczane fiyatı ne kadar?
Cipro 500 mg Nedir?
Cipro 500 mg, etken maddesi siprofloksasin olan, florokinolon grubuna ait bir antibiyotiktir. Bakterilerin çoğalmasını ve hayatta kalmasını sağlayan mekanizmaları durdurarak enfeksiyonla mücadele eder. Yalnızca bakterilere karşı etkilidir.
Ne İşe Yarar, Hangi Hastalıklarda Kullanılır?
Cipro 500 mg; doktorun uygun gördüğü durumlarda aşağıdaki bakteriyel enfeksiyonların tedavisinde kullanılır:
İdrar yolu enfeksiyonları
Solunum yolu enfeksiyonları
Sinüs ve kulak enfeksiyonları
Cilt ve yumuşak doku enfeksiyonları
Sindirim sistemi kaynaklı bazı enfeksiyonlar
Viral hastalıklarda (grip, nezle gibi) etkili değildir.
Kimler Kullanır?
Cipro 500 mg, yalnızca doktor reçetesiyle ve bakteriyel enfeksiyon tanısı konulan kişiler tarafından kullanılır. Çocuklar, hamileler, emzirenler ve bazı kronik hastalığı olan bireyler için kullanımı doktor değerlendirmesi gerektirir.
Cipro 500 mg Fiyatı Ne Kadar?
Cipro 500 mg’nin 14 tabletlik formunun Türkiye’de eczanelerdeki güncel satış fiyatı, eczaneye ve zamana bağlı olarak değişmekle birlikte yaklaşık 170–200 TL aralığındadır. Reçete ve SGK durumuna göre fiyat farklılık gösterebilir.
Kullanımda Dikkat Edilmesi Gerekenler
Cipro 500 mg, doktorun belirlediği doz ve sürede kullanılmalıdır. Tedavi yarıda kesilmemeli, başka ilaçlarla birlikte kullanımda sağlık profesyoneline bilgi verilmelidir. Olası yan etkiler görüldüğünde hekime başvurulmalıdır.
ÖNEMLİ UYARI: Doktor onayı olmadan reçetesiz sadece haberlere bakarak asla ilaç almayın. Sağlığınız için tehlikelidir. Bu uyarıyı dikkate alın ve bu sadece bir haberdir Asla önermez, asla faydalı olduğunu söylemez. Haberlere asla inanmayın doktorunuza sorun!